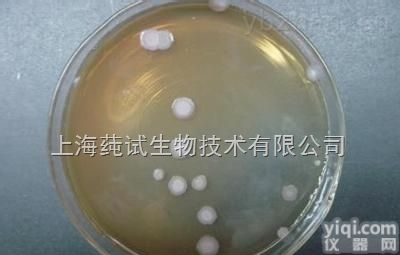
<em>绿色木霉=木素木霉价格</em>

中文名称
绿色木霉=木素木霉价格属名 Trichoderma
种名加词 viride
收藏时间
原始编号 ATCC30048
模式菌株 非模式菌株
主要用途 a:5:{i:0;s:4:分类;i:1;s:4:研究;i:2;s:4:教学;i:3;s:8:分析检测;i:4;s:4:生产;}
特征特性 在PDA琼脂培养基上生长,菌落开始白色,后变成绿色。分生孢子梗瓶形或锥形,分生孢子椭圆形或近球形,产孢子多。
具体用途
生物危害程度 四类
 绿色木霉=木素木霉价格
绿色木霉=木素木霉价格低温保存法:
1.简单保存法,将琼脂斜面孢子培养物、菌丝悬浮液以及由麸皮、大米、小米等谷物原料制成的孢子培养物置于4℃冰箱保存,保存时间不超过1~2个月,若将谷物原料制备的孢子瓶抽真空并在棉塞上浸蜡,以隔绝外界空气和水汽,保持时间可达3~4个月。
2.液氮超低温保存法,将生长稳定期的细胞悬浮在10%甘油或其他低冰点液体中,密封于安瓿管内,然后控制冷却速度,使安瓿管温度逐步下降至-35℃时,即可置于-150~-196℃的液氮罐中保存。大多数微生物如病毒、噬菌体、多种细菌、放线菌、酵母和原虫、特别是一些用冷冻干燥法有困难的微生物,都可用此法长期保存。
绿色木霉=木素木霉价格保藏方法
1. 传代培养保藏法
又有斜面培养、穿刺培养、疱肉培养基培养等(后者作保藏厌氧细菌用),培养后于4-6℃冰箱内保存。
2. 液体石蜡覆盖保藏法
是传代培养的变相方法,能够适当延长保藏时间,它是在斜面培养物和穿刺培养物上面覆盖灭菌的液体石蜡,一方面可防止因培养基水分蒸发而引起菌种死亡,另一方面可阻止氧气进入,以减弱代谢作用。
3. 载体保藏法
是将微生物吸附在适当的载体,如土壤、沙子、硅胶、滤纸上,而后进行干燥的保藏法,例如沙土保藏法和滤纸保藏法应用相当广泛。
4. 寄主保藏法
用于目前尚不能在人工培养基上生长的微生物,如病毒、立克次氏体、螺旋体等,它们必须在生活的动物、昆虫、鸡胚内感染并传代,此法相当于一般微生物的传代培养保藏法。病毒等微生物亦可用其他方法如液氮保藏法与冷冻干燥保藏法进行保藏。
5. 冷冻保藏法
可分低温冰箱(-20-30℃,-50-80℃)、干冰酒精快速冻结(约-70℃)和液氮(-196℃)等保藏法。
6. 冷冻干燥保藏法
先使微生物在极低温度(-70℃左右)下快速冷冻,然后在减压下利用升华现象除去水分(真空干燥)。有些方法如滤纸保藏法、液氮保藏法和冷冻干燥保藏法等均需使用保护剂来制备细胞悬液,以防止因冷冻或水分不断升华对细胞的损害。保护性溶质可通过氢和离子键对水和细胞所产生的亲和力来稳定细胞成分的构型。保护剂有牛乳、血清、糖类、甘油、二甲亚砜等。
绿色木霉=木素木霉价格使用范围:
(1)合成培养基。合成培养基的各种成分完全是已知的各种化学物质。这种培养基的化学成分清楚,酿酒酵母菌组成成分精确,重复性强,而且微生物在这类培养基中生长较慢。如高氏一号合成培养基、察氏(Czapek)培养基等。
(2)天然培养基。由天然物质制成,如蒸熟的马铃薯和普通牛肉汤,前者用于培养霉菌,后者用于培养细菌。这类培养基的化学成分很不恒定,也难以确定,但配制方便,营养丰富,培养效果好,所以常被采用。
(3)半合成培养基。在天然有机物的基础上适当加入已知成分的无机盐类,或在合成培养基的基础上添加某些天然成分,如培养霉菌用的马铃薯葡萄糖琼脂培养基。这类培养基能更有效地满足微生物对营养物质的需要。
枸橼酸锌 对照品 原子吸收法溶出度检查 M96871 100351-200301 100mg
卡莫氟 对照品 含量测定 M96872 100352-200301 50mg
奥沙普秦 对照品 UV法含量测定用 M96873 100353-200301 50mg
尼可占替诺(烟酸占替诺) 对照品 UV法含量测定 M96874 100356-200401 100mg
盐酸帕罗西汀 对照品 含量测定(HPLC) M96875 100357-200301 100mg
卡巴胆碱 对照品 UV法含量测定用 M96876 100361-200301 30mg
西洛他唑 对照品 含量测定 M96877 100363-200301 50mg
氯唑沙宗 对照品 HPLC法含量测定用 M96878 100364-200301 50mg
茴拉西坦 对照品 HPLC法含量测定 M96879 100365-200401 100mg
卡络磺钠 对照品 鉴别(IR) M96880 100366-200301 50mg
奥美拉唑 对照品 含量测定(HPLC) M96881 100367-200501 100mg
维生素B2 对照品 HPLC法含量测定用 M96882 100369-200301 50mg
泛酸钙 对照品 HPLC含量测定 M96883 100370-200301 50mg
乌苯美司 对照品 含量测定 M96884 100371-200301 50mg
阿苯达唑 对照品 含量测定 M96885 100373-200301 50mg
Human staphylococcus aureus enterotoxins,SE ELISA Kit 人促甲状腺激素受体抗体(TSHR)ELISA Kit,48T/96T
Human beta cellulin,BTC ELISA Kit 小鼠高灵敏度促甲状腺激素(U-TSH)ELISA Kit,48T/96T
Human placental ribo
nuclease inhibitor,HPRI ELISA Kit 大鼠高灵敏度促甲状腺激素(U-TSH)ELISA Kit,48T/96T
Human placenta lactogen,HPL ELISA Kit 人高敏甲状腺素(u-T4)ELISA Kit,48T/96T
Human anti-cytomegalovirus IgM antibody,anti-CMV IgM ELISA Kit 小鼠高敏甲状腺素(u-T4)ELISA Kit,48T/96T
Human anti-cytomegalovirus IgM antibody,anti-CMV IgM ELISA Kit 大鼠高敏甲状腺素(u-T4)ELISA Kit,48T/96T
Human anti-toxoplasma IgG antibody,anti-tox IgG ELISA Kit 犬主要组织相容性复合体(MHC/DLA)ELISA Kit,48T/96T
绿色木霉=木素木霉价格Human Neo
natal Thyroid Stimulating Hormone,N-TSH ELISA Kit 豚鼠主要组织相容性复合体(MHC/GPLA)ELISA Kit,48T/96T
Human Pregnancy Specificβ1Glycoprotein,SP1/PSβ1-G ELISA Kit 人主要组织相容性复合体Ⅰ类(MHCⅠ/HLAⅠ)ELISA Kit,48T/96T
Human placetal lactogen,PL ELISA Kit 小鼠主要组织相容性复合体Ⅰ类(MHCⅠ/H-2Ⅰ)ELISA Kit,48T/96T
Human Androgen Binding Protein,ABP ELISA Kit 猪主要组织相容性复合体Ⅰ类(MHCⅠ/SLAⅠ)ELISA Kit,48T/96T
Human anti-trophoblast antibody,ATA ELISA Kit 大鼠主要组织相容性复合体Ⅰ类(MHCⅠ/H-1Ⅰ)
Human anti-zona pellucida antibody,aZP ELISA Kit